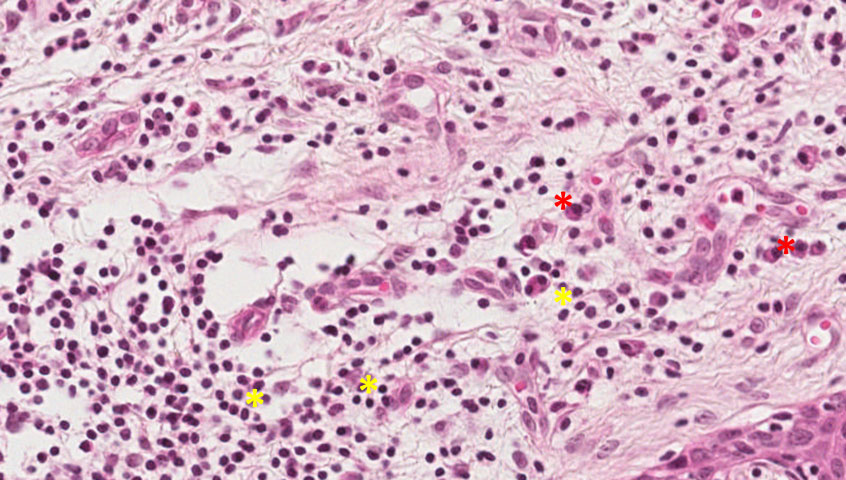

Conceito: A inflamação é uma resposta defensiva local, frente a ação de agentes lesivos, caracterizada por uma sequência de fênomenos irritativos, vasculares, exudativos, degenerativos necróticos e produtivos reparativos acompanhados ou não por reação geral do organismo. Podem ser classificados clinicamente e histopatologicamente em agudos e crônicos.
| Inflamação Aguda | Inflamação Crônica | |
|---|---|---|
| Tempo | Curto (horas-dias) | Longo (semanas, meses, anos) |
| Agente agressor | Alta patogenicidade | Baixa patogenicidade |
| Tipo de dor | Presente – intensidade variável | Ausente ou baixa intensidade |
| Células | Neutrófilos | Linfócitos, plasmócitos e macrófagos |
| Fenômenos | Vasculares e exsudativos resultando em hiperemia e edema | Proliferativos que resulta em fibroplasia e angiogênese |
OBS: Dependendo de modificações no agente agressor ou na capacidade de resposta do hospedeiro, a inflamação aguda pode cronificar ou a inflamação crônica pode agudizar. Existem situações aonde são observadas características de ambas e, portanto, são denominadas de inflamação crônica com agudização.
Fragmento de mucosa revestido por tecido epitelial estratificado pavimentoso ceratinizado. No tecido conjuntivo subjacente observa-se hiperemia, caracterizada por dilatados e congestos (asteriscos pretos), trombos - degeneração hialina intra-vascular (asteriscos vermelhos), edema peri-vascular, áreas de fibroplasia e angiogênese - células endoteliais jovens são mais volumosas (asteriscos vermelhos). Observarmos predomínio de plasmócitos e linfócitos e escassos neutrófilos.
Observar fenômenos característicos de inflamação aguda como hiperemia (aumento de vasos funcionantes), exsudato/edema e infiltrado de neutrófilos, associados a eventos crônicos como angiogênese (asteriscos verdes), fibroplasia, infiltrado de plasmócitos e linfócitos.
Granuloma Piogênico


Fragmento de mucosa revestido por tecido epitelial estratificado pavimentoso ceratinizado. Subjacente a ele, vemos o tecido conjuntivo com intensa fibroplasia, angiogênese e células inflamatórias crônicas (linfócitos, plasmócitos e macrófagos).
Angiogênese (setas A), fibroplasia (setas B), infiltrado de linfócitos (asterisco amarelo) e plasmócitos (asterisco vermelho) → Tecido de granulação.
Hiperplasia Inflamatória.

Nesta lâmina observam-se três zonas principais:
Presença de pus colecionado (área aguda) envolto por capsula fibrosa e infiltrado linfoplasmocitário (área crônica).
Abscesso crônico.

